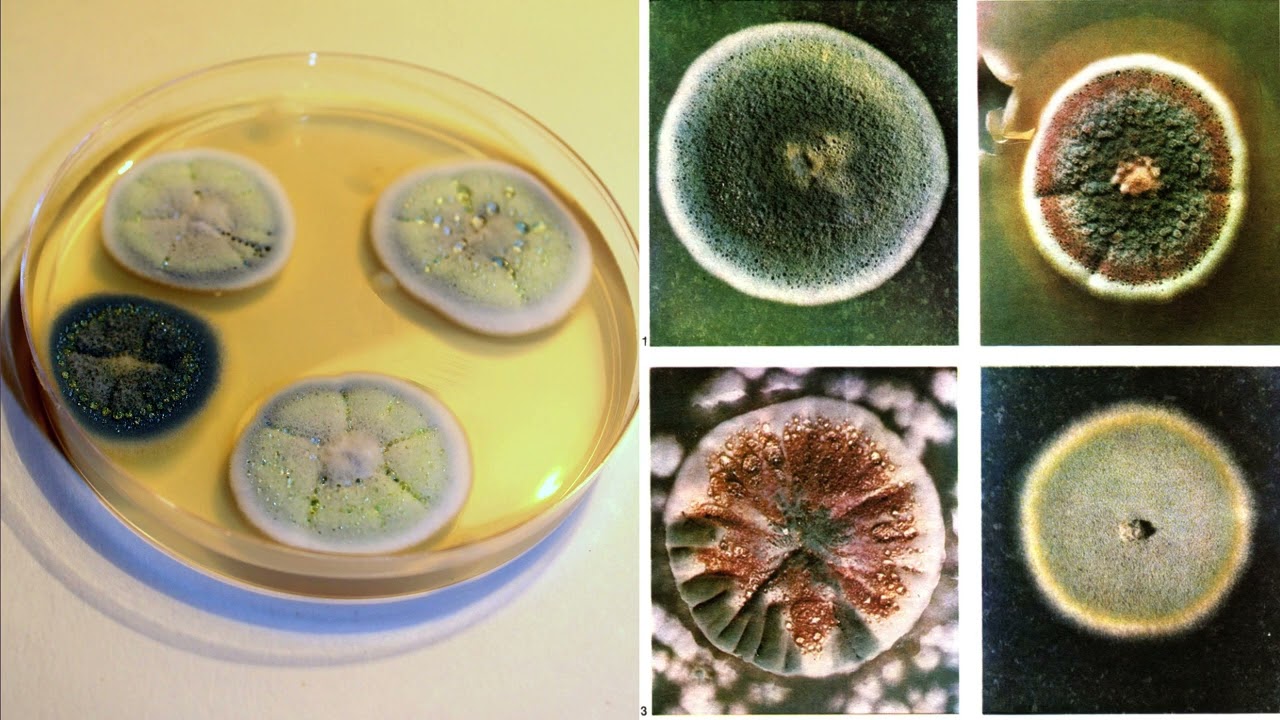

Класс несовершенные грибы
Порошок гектор от клопов инструкция
Bell 47
Расписание 39 кемерово
Indigo на границе империй 7 2
Пассивный залог презент континиус
Охлаждение подручными средствами
Новости г стерлитамак
Что говорит печорин о храбрости
Боли при хроническом гастродуодените
Почему машина глохнет на механике
Мачеха заигрывает
Как получить процент с покупки квартиры
30 49 83
Класс несовершенные грибы 112 фотографий